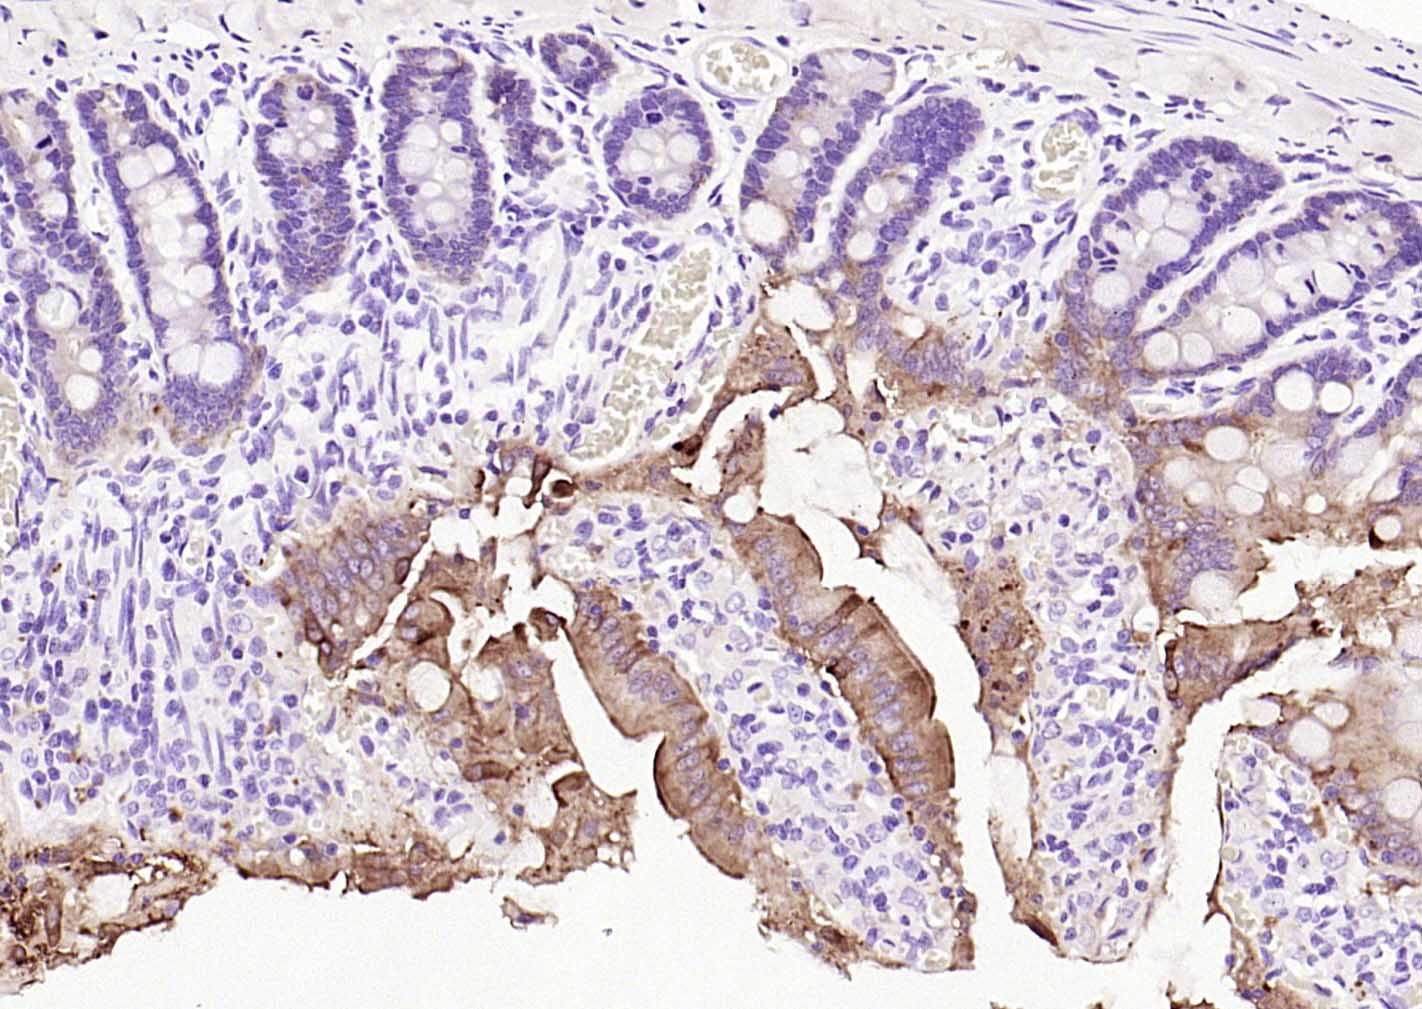
绒毛蛋白重组兔单抗

绒毛蛋白重组兔单抗
Rrmab?兔单抗

货号:bsm-54212R
产品详情
相关标记
相关产品
相关文献
常见问题
概述
产品编号
bsm-54212R
产品类型
重组兔单抗
英文名称
villin Recombinant Rabbit mAb
中文名称
绒毛蛋白重组兔单抗
英文别名
D2S1471; VIL; VILI_HUMAN; VIL1; VILI_MOUSE;
抗体来源
Rabbit
免疫原
Recombinant human villin protein
亚型
IgG
性状
Liquid
纯化方法
affinity purified by Protein A
克隆类型
Recombinant
克隆号
6G2
理论分子量
93 kDa
浓度
1mg/ml
储存液
0.01M TBS (pH7.4) with 1% BSA, 0.02% Proclin300 and 50% Glycerol.
研究领域
SWISS
Gene ID
保存条件
Shipped at 4℃. Store at -20℃ for one year. Avoid repeated freeze/thaw cycles.
注意事项
This product as supplied is intended for research use only, not for use in human, therapeutic or diagnostic applications.
数据库链接
产品介绍
绒毛蛋白(Villin)是一种分子量为93-95kDa的肌动蛋白相关钙调节蛋白,正常分布于肠上皮和肾近曲小管上皮,可用于胃肠道神经内分泌肿瘤诊断的参考指标。
背景资料
Villin can cap, nucleate, sever and bundle actin in a calcium and phosphoinositide regulated manner. It is associated with the microvillar actin core bundle of intestinal and renal brush border implicated in adsorption. Villin is composed of six repeats, each containing 150 residues that together constitute the core domain followed by the carboxyl terminal headpiece domain of 87 residues. The core domain retains the calcium dependent capping nucleating and severing activity, whereas the headpiece domain contributes towards actin filament bundling and binding F actin, independently of Calcium.
Function : Epithelial cell-specific Ca(2+)-regulated actin-modifying protein that modulates the reorganization of microvillar actin filaments. Plays a role in the actin nucleation, actin filament bundle assembly, actin filament capping and severing. Binds phosphatidylinositol 4,5-bisphosphate (PIP2) and lysophosphatidic acid (LPA); binds LPA with higher affinity than PIP2. Binding to LPA increases its phosphorylation by SRC and inhibits all actin-modifying activities. Binding to PIP2 inhibits actin-capping and -severing activities but enhances actin-bundling activity. Regulates the intestinal epithelial cell morphology, cell invasion, cell migration and apoptosis. Protects against apoptosis induced by dextran sodium sulfate (DSS) in the gastrointestinal epithelium. Appears to regulate cell death by maintaining mitochondrial integrity. Enhances hepatocyte growth factor (HGF)-induced epithelial cell motility, chemotaxis and wound repair. Upon S.flexneri cell infection, its actin-severing activity enhances actin-based motility of the bacteria and plays a role during the dissemination.

产品应用
| 应用 | 已检合格种属 | 预测种属 | 推荐稀释比例 |
|---|---|---|---|
| WB | Mouse, Rat | Human | 1:500-1000 |
| IHC-P | Human, Mouse, Rat | 1:20-200 | |
| IHC-F | Human, Mouse, Rat | 1:20-200 | |
| IF | Human, Mouse, Rat | 1:50-200 |
交叉反应
交叉反应: Human, Mouse, Rat
相关产品
暂无相关产品
靶标
基因名
VIL1
蛋白名
Villin-1
亚基
Monomer. Homodimer; homodimerization is necessary for actin-bundling. Associates with F-actin; phosphorylation at tyrosines residues decreases the association with F-actin. Interacts (phosphorylated at C-terminus tyrosine phosphorylation sites) with PLCG1 (via the SH2 domains). Interacts (phosphorylated form) with PLCG1; the interaction is enhanced by hepatocyte growth factor (HGF) (By similarity).
亚细胞定位
Cytoplasm, cytoskeleton. Cell projection, lamellipodium. Cell projection, ruffle. Cell projection, microvillus. Cell projection, filopodium tip (By similarity). Cell projection, filopodium (By similarity). Note=Relocalized in the tip of cellular protrusions and filipodial extensions upon infection with S.flexneri in primary intestinal epithelial cells (IEC) and in the tail-like structures forming the actin comets of S.flexneri. Redistributed to the leading edge of hepatocyte growth factor (HGF)-induced lamellipodia (By similarity). Rapidly redistributed to ruffles and lamellipodia structures in response to autotaxin, lysophosphatidic acid (LPA) and epidermal growth factor (EGF) treatment.
组织特异性
Specifically expressed in epithelial cells. Major component of microvilli of intestinal epithelial cells and kidney proximal tubule cells. Expressed in canalicular microvilli of hepatocytes (at protein level).
翻译后修饰
Tyrosine phosphorylation is induced by epidermal growth factor (EGF) and stimulates cell migration (By similarity). Phosphorylated on tyrosine residues by SRC. The unphosphorylated form increases the initial rate of actin-nucleating activity, whereas the tyrosine-phosphorlyated form inhibits actin-nucleating activity, enhances actin-bundling activity and enhances actin-severing activity by reducing high Ca(2+) requirements. The tyrosine-phosphorlyated form does not regulate actin-capping activity. Tyrosine phosphorylation is essential for cell migration: tyrosine phosphorylation sites in the N-terminus half regulate actin reorganization and cell morphology, whereas tyrosine phosphorylation sites in the C-terminus half regulate cell migration via interaction with PLCG1.
疾病
Note=Biliary atresia is a chronic and progressive cholestatic liver disease of chilhood characterized by an abnormal villin gene expression and severe malformation of canalicular microvillus structure.
相似性
Belongs to the villin/gelsolin family.
Contains 6 gelsolin-like repeats.
Contains 1 HP (headpiece) domain
Contains 6 gelsolin-like repeats.
Contains 1 HP (headpiece) domain
功能
Epithelial cell-specific Ca(2+)-regulated actin-modifying protein that modulates the reorganization of microvillar actin filaments. Plays a role in the actin nucleation, actin filament bundle assembly, actin filament capping and severing. Binds phosphatidylinositol 4,5-bisphosphate (PIP2) and lysophosphatidic acid (LPA); binds LPA with higher affinity than PIP2. Binding to LPA increases its phosphorylation by SRC and inhibits all actin-modifying activities. Binding to PIP2 inhibits actin-capping and -severing activities but enhances actin-bundling activity. Regulates the intestinal epithelial cell morphology, cell invasion, cell migration and apoptosis. Protects against apoptosis induced by dextran sodium sulfate (DSS) in the gastrointestinal epithelium. Appears to regulate cell death by maintaining mitochondrial integrity. Enhances hepatocyte growth factor (HGF)-induced epithelial cell motility, chemotaxis and wound repair. Upon S.flexneri cell infection, its actin-severing activity enhances actin-based motility of the bacteria and plays a role during the dissemination.
标记抗体
暂无标记数据
同靶标产品
暂无同靶标产品
相关文献
提示: 发表研究结果有使用 bsm-54212R 时请让我们知道,以便我们可以引用参考文章。作为回馈,资料提供者将获得我们送上的小礼品。
具体参考文献:bsm-54212R 被引用于1文献中
暂无相关文献
常见问题
暂无常见问题